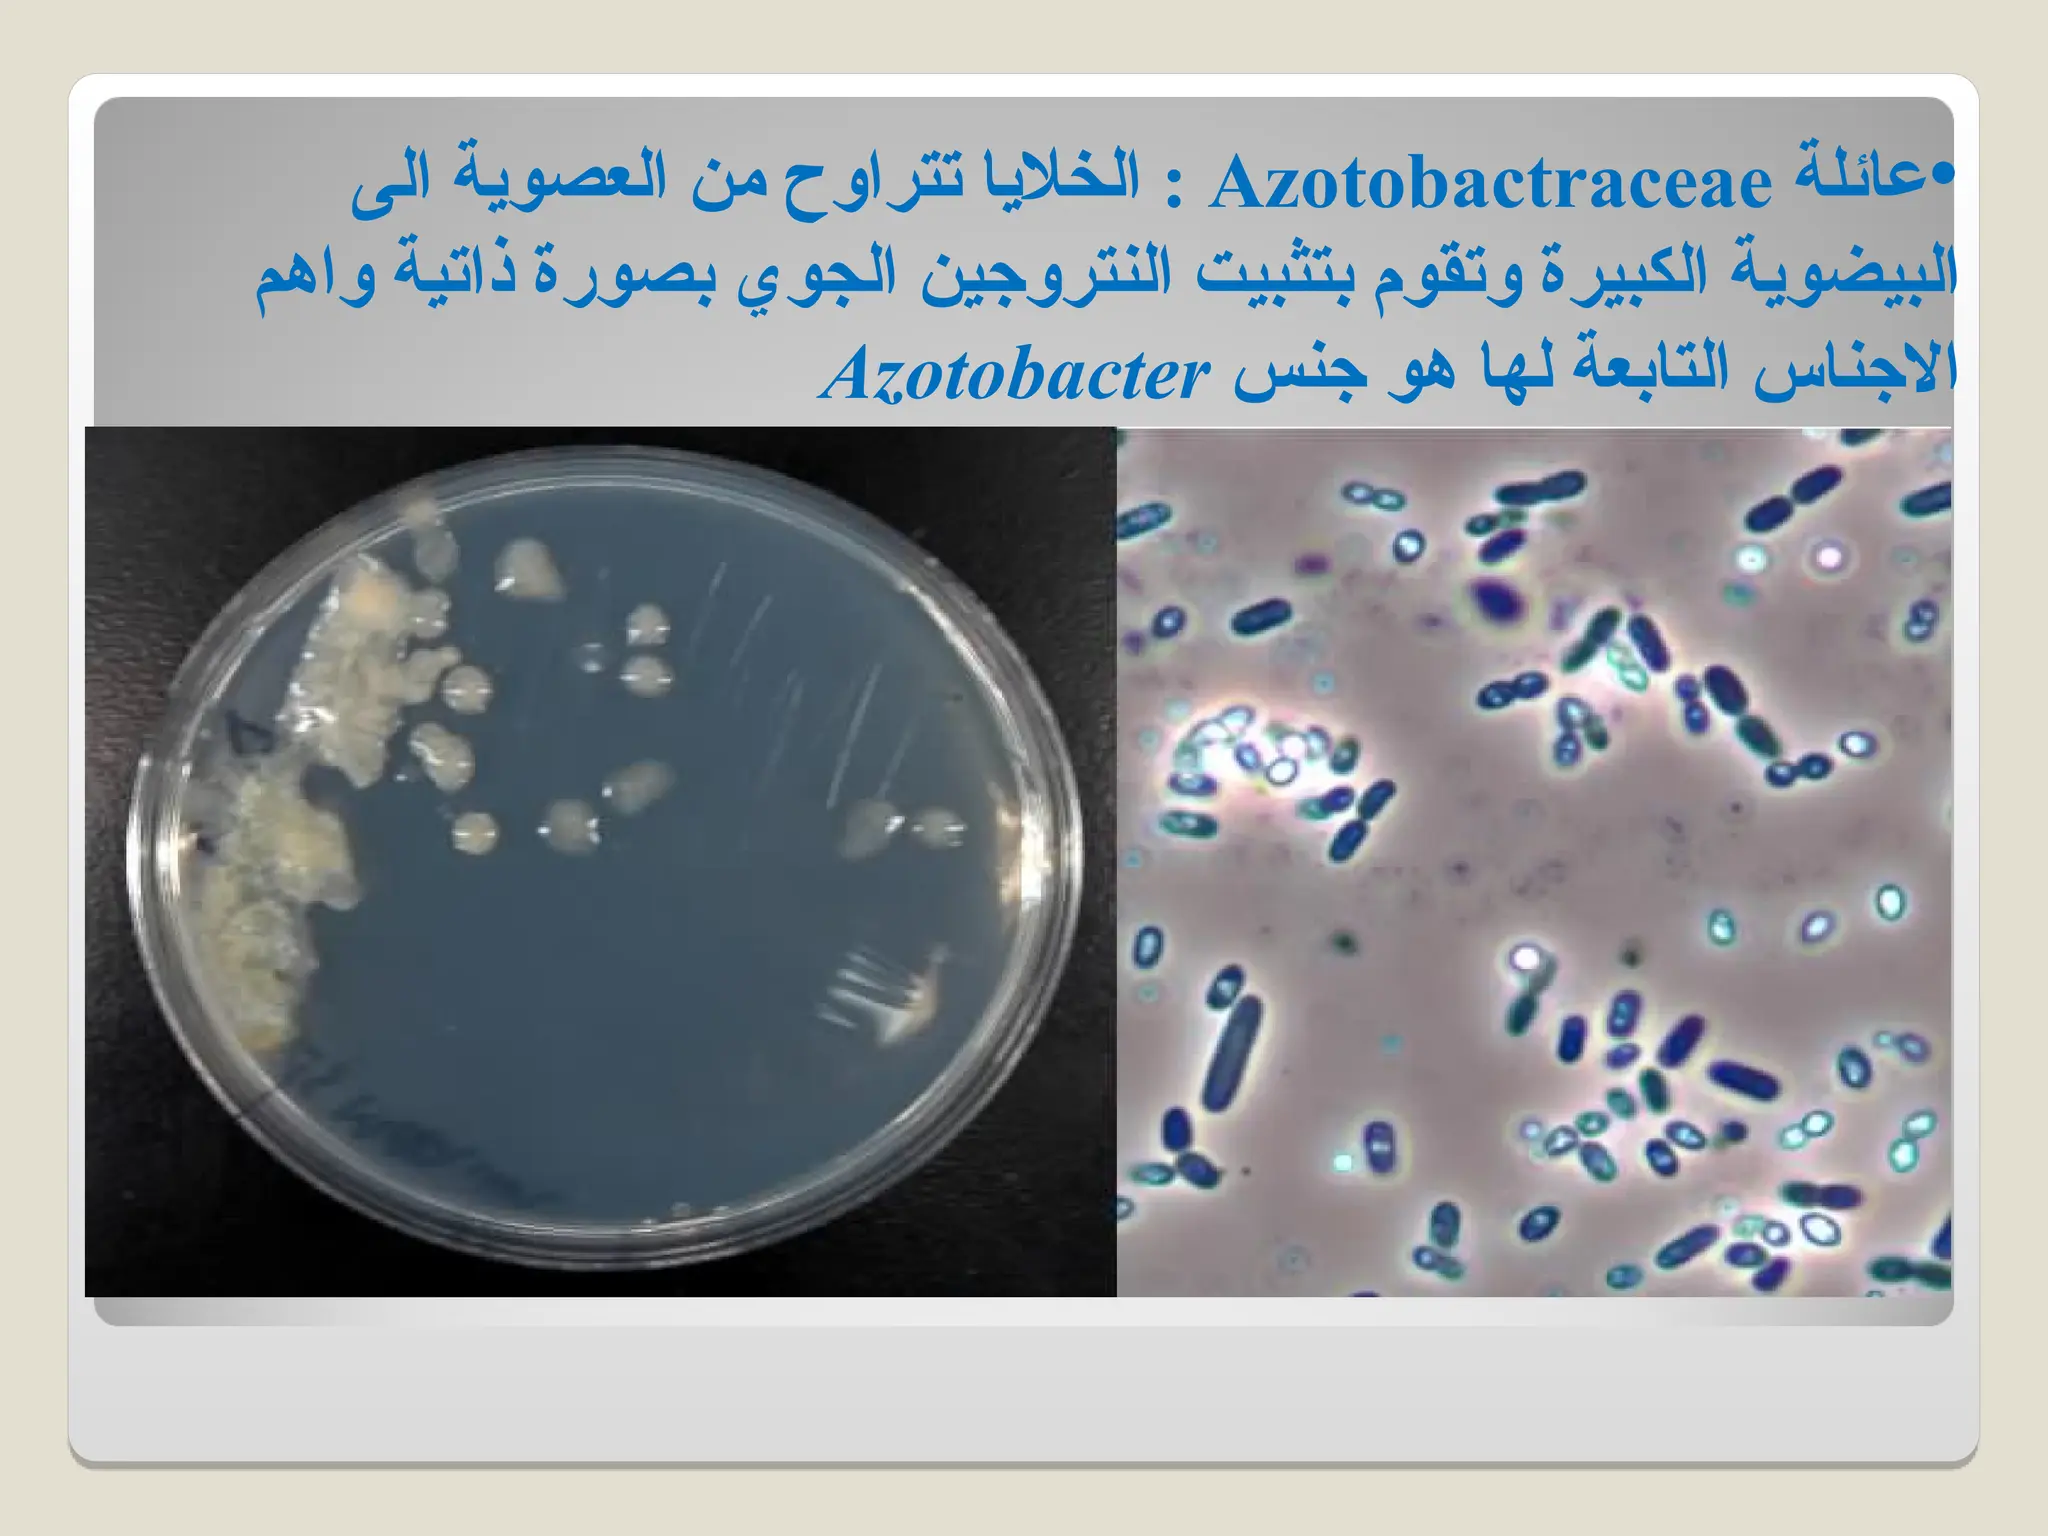
•
‫عائلة‬
Azotobactraceae
‫الى‬ ‫العصوية‬ ‫من‬ ‫تتراوح‬ ‫الخاليا‬ :
‫واهم‬ ‫ذاتية‬ ‫بصورة‬ ‫الجوي‬ ‫النتروجين‬ ‫بتثبيت‬ ‫وتقوم‬ ‫الكبيرة‬ ‫البيضوية‬
‫جنس‬ ‫هو‬ ‫لها‬ ‫التابعة‬ ‫االجناس‬
Azotobacter

أهمية دراسة الكائنات الدقيقة
تلعب الكائنات الدقيقة دوراً هاما إعادة إستخدام مياه الصرف.
تلعب الكائنات الدقيقة دوراً في إنتاج الكيميائيات الحيوية.
تلعب الكائنات الدقيقة دوراً في التقنية الحيوية الطبية.
تلعب الكائنات الدقيقة دوراً التقنية الحيوية الغذائية.
تلعب الكائنات الدقيقة دوراً التعدين الميكروبي.
تلعب الكائنات الدقيقة دوراً التقنية الحيوية الزراعية.
تلعب الكائنات الدقيقة دوراً في الإنتاج الميكروبي للكيميائيات والوقود.
تلعب الكائنات الدقيقة دوراً في إنتاج البروتينات وحيدة الخلية.
تلعب الكائنات الدقيقة دوراً في الامتصاص الحيوي للملوثات المعدنية.
تلعب الكائنات الدقيقة دوراً في صناعة الورق .
تلعب الكائنات الدقيقة دوراً فى جميع الصناعات الحياتية كما سيذكر فى هذا المقرر.